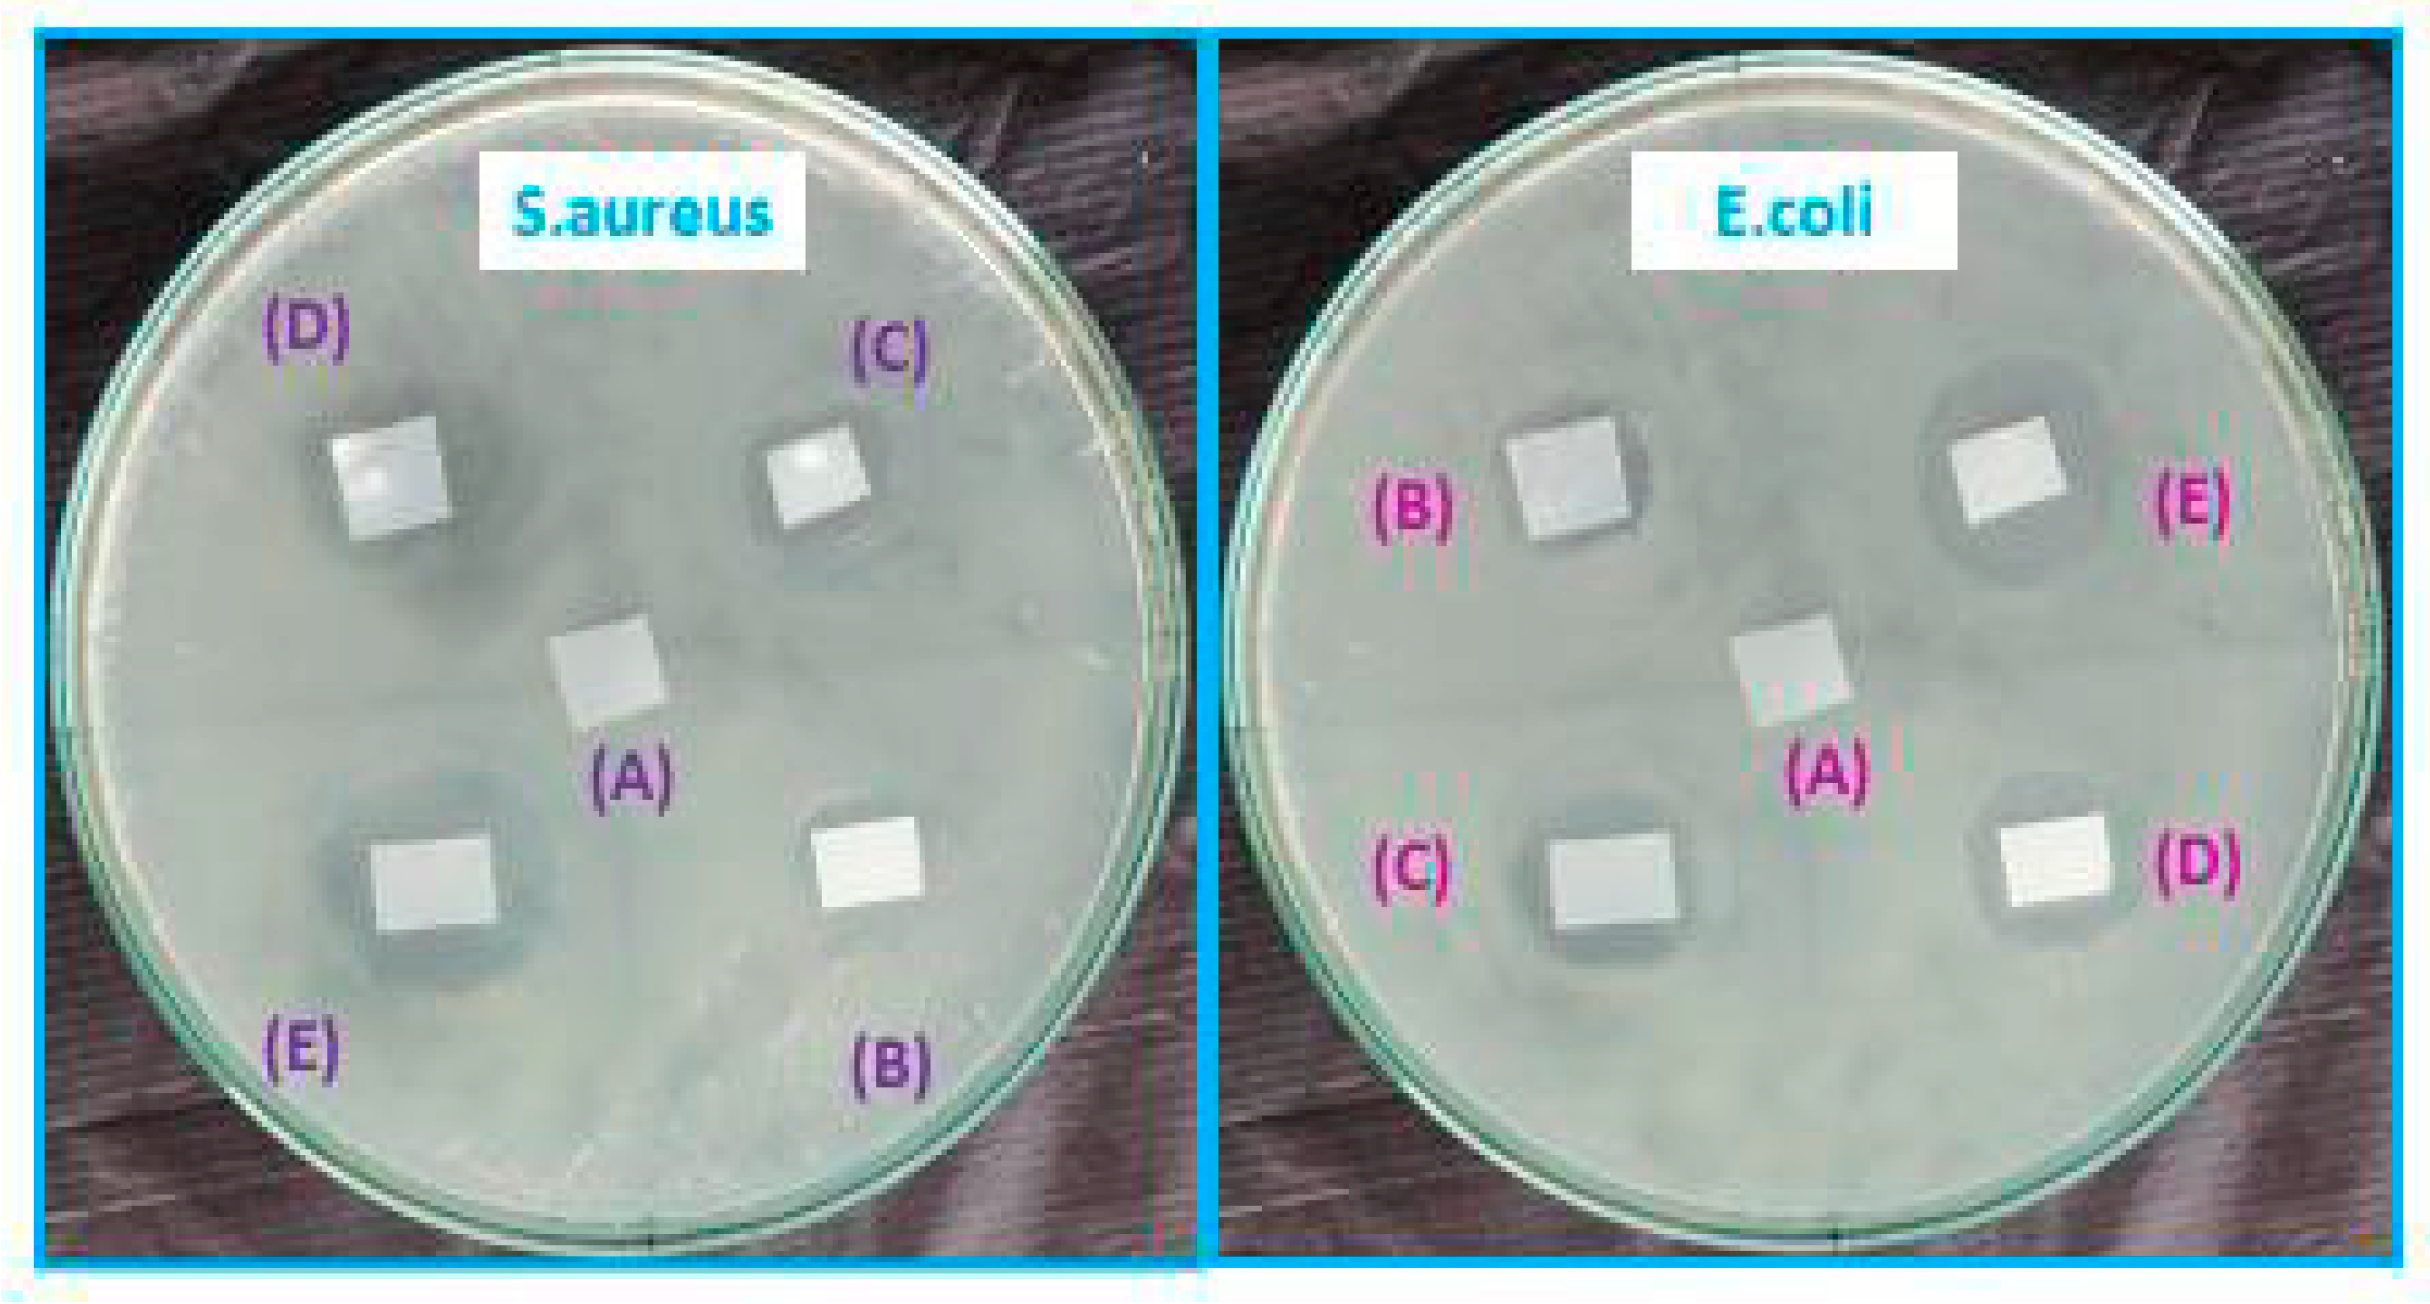
Sustainability 14 08073 g008

Effect of Low Concentration of SiO2 Nanoparticles on Grape Seed Essential Oil/PBAT Composite Films for Sustainable Food Packaging Application
Abstract
:1. Introduction
2. Materials and Methods
2.1. Materials
2.2. Preparation of PBAT/GEO/SiO2 Nanocomposite Film
2.3. Characterizations
2.3.1. FTIR Analysis
2.3.2. XRD Analysis
2.3.3. Morphological Study
2.3.4. TGA Analysis
2.3.5. Mechanical Properties
2.3.6. Barrier Properties
2.3.7. Optical Properties of Film
2.3.8. Water Contact Angle of Film
2.3.9. Antimicrobial Activity
3. Results and Discussion
3.1. FTIR Analysis
3.2. XRD Analysis
3.3. Morphological Characterization
3.4. Thermal Analysis
3.5. Mechanical Properties
3.6. Barrier Properties
3.7. Water Contact Angle Measurement
3.8. Film Color and Opacity
3.9. Antimicrobial Activity
4. Conclusions
Author Contributions
Funding
Institutional Review Board Statement
Informed Consent Statement
Data Availability Statement
Conflicts of Interest
References
- Hailu, M.; Workneh, T.S.; Belew, D. Effect of packaging materials on shelf life and quality of banana cultivars (Musa spp.). J. Food Sci. Technol. 2012, 51, 2947–2963. [Google Scholar] [CrossRef] [PubMed] [Green Version]
- Radusin, T.; Tomšik, A.; Šarić, L.; Ristić, I.; Baschetti, M.G.; Minelli, M.; Novaković, A. Hybrid Pla/wild garlic antimicrobial composite films for food packaging application. Polym. Compos. 2018, 40, 893–900. [Google Scholar] [CrossRef]
- Didone, M.; Saxena, P.; Brilhuis-Meijer, E.; Tosello, G.; Bissacco, G.; Mcaloone, T.C.; Pigosso, D.C.A.; Howard, T.J. Moulded pulp manufacturing: Overview and prospects for the process technology. Packag. Technol. Sci. 2017, 30, 231–249. [Google Scholar] [CrossRef] [Green Version]
- Qian, M.; Liu, D.; Zhang, X.; Yin, Z.; Ismail, B.B.; Ye, X.; Guo, M. A review of active packaging in bakery products: Applications and future trends. Trends Food Sci. Technol. 2021, 114, 459–471. [Google Scholar] [CrossRef]
- Wang, J.; Euring, M.; Ostendorf, K.; Zhang, K. Biobased materials for food packaging. J. Bioresour. Bioprod. 2021, 7, 1–13. [Google Scholar] [CrossRef]
- Garavand, F.; Cacciotti, I.; Vahedikia, N.; Rehman, A.; Tarhan, Ö.; Akbari-Alavijeh, S.; Shaddel, R.; Rashidinejad, A.; Nejatian, M.; Jafarzadeh, S. A comprehensive review on the nanocomposites loaded with chitosan nanoparticles for food packaging. Crit. Rev. Food Sci. Nutr. 2020, 62, 1383–1416. [Google Scholar] [CrossRef]
- Saxena, P.; Bissacco, G.; Meinert, K.Æ.; Bedka, F.J. Mold design and fabrication for production of thermoformed paper-based packaging products. J. Manuf. Process. 2020, 58, 311–321. [Google Scholar] [CrossRef]
- Reichert, C.L.; Bugnicourt, E.; Coltelli, M.-B.; Cinelli, P.; Lazzeri, A.; Canesi, I.; Braca, F.; Martínez, B.M.; Alonso, R.; Agostinis, L.; et al. Bio-Based Packaging: Materials, Modifications, Industrial Applications and Sustainability. Polymers 2020, 12, 1558. [Google Scholar] [CrossRef]
- Chausali, N.; Saxena, J.; Prasad, R. Recent trends in nanotechnology applications of bio-based packaging. J. Agric. Food Res. 2021, 7, 100257. [Google Scholar] [CrossRef]
- Azeredo, H.M.C.; Rosa, M.F.; Mattoso, L.H.C. Nanocellulose in bio-based food packaging applications. Ind. Crops Prod. 2017, 97, 664–671. [Google Scholar] [CrossRef]
- Niranjana Prabhu, T.; Prashantha, K. A review on present status and future challenges of starch based polymer films and their composites in food packaging applications. Polym. Compos. 2018, 39, 2499–2522. [Google Scholar] [CrossRef]
- Varshney, S.; Mishra, N.; Gupta, M. Progress in nanocellulose and its polymer based composites: A review on processing, characterization, and applications. Polym. Compos. 2021, 42, 3660–3686. [Google Scholar] [CrossRef]
- Zhuang, C.; Tao, F.; Cui, Y. Eco-friendly biorefractory films of gelatin and TEMPO-oxidized cellulose ester for food packaging application. J. Sci. Food Agric. 2017, 97, 3384–3395. [Google Scholar] [CrossRef] [PubMed]
- Subbuvel, M.; Kavan, P. Preparation and characterization of polylactic acid/fenugreek essential oil/curcumin composite films for food packaging applications. Int. J. Biol. Macromol. 2021, 194, 470–483. [Google Scholar] [CrossRef] [PubMed]
- Yao, Q.; Song, Z.; Li, J.; Zhang, L. Micromorphology, mechanical, crystallization and permeability properties analysis of HA/PBAT/PLA (HA, hydroxyapatite; PBAT, poly(butylene adipate-co-butylene terephthalate); PLA, polylactide) degradability packaging films. Polym. Int. 2019, 69, 301–307. [Google Scholar] [CrossRef]
- Lu, W.; Cui, R.; Zhu, B.; Qin, Y.; Cheng, G.; Li, L.; Yuan, M. Influence of clove essential oil immobilized in mesoporous silica nanoparticles on the functional properties of poly (lactic acid) biocomposite food packaging film. J. Mater. Res. Technol. 2021, 11, 1152–1161. [Google Scholar] [CrossRef]
- Thiyagu, T.T.; Rajeswari, N. Effect of nanosilica and neem tree oil on antimicrobial, thermal, mechanical and electrical insulate of biodegradable composite film. Mater. Res. Express 2019, 6, 095410. [Google Scholar] [CrossRef]
- Sharma, B.; Malik, P.; Jain, P. Biopolymer reinforced nanocomposites: A comprehensive review. Mater. Today Commun. 2018, 16, 353–363. [Google Scholar] [CrossRef]
- Priyadarshi, R.; Roy, S.; Ghosh, T.; Biswas, D.; Rhim, J.W. Antimicrobial nanofillers reinforced biopolymer composite films for active food packaging applications-a review. Sustain. Mater. Technol. 2021, 3, e00353. [Google Scholar] [CrossRef]
- Luo, Q.; Hossen, A.; Zeng, Y.; Dai, J.; Li, S.; Qin, W.; Liu, Y. Gelatin-based composite films and their application in food packaging: A review. J. Food Eng. 2021, 313, 110762. [Google Scholar] [CrossRef]
- Lyu, J.S.; Lee, J.-S.; Han, J. Development of a biodegradable polycaprolactone film incorporated with an antimicrobial agent via an extrusion process. Sci. Rep. 2019, 9, 20236. [Google Scholar] [CrossRef] [PubMed]
- Lim, G.-O.; Jang, S.-A.; Bin Song, K. Physical and antimicrobial properties of Gelidium corneum/nano-clay composite film containing grapefruit seed extract or thymol. J. Food Eng. 2010, 98, 415–420. [Google Scholar] [CrossRef]
- Kanmani, P.; Rhim, J.-W. Development and characterization of carrageenan/grapefruit seed extract composite films for active packaging. Int. J. Biol. Macromol. 2014, 68, 258–266. [Google Scholar] [CrossRef]
- Rubilar, J.F.; Cruz, R.M.; Khmelinskii, I.; Vieira, M.C. Effect of antioxidant and optimal antimicrobial mixtures of carvacrol, grape seed extract and chitosan on different spoilage microorganisms and their application as coatings on different food matrices. Int. J. Food Stud. 2013, 2, 22–38. [Google Scholar] [CrossRef]
- Wang, L.F.; Rhim, J.W. Grapefruit seed extract incorporated antimicrobial LDPE and PLA films: Effect of type of polymer matrix. LWT 2016, 74, 338–345. [Google Scholar] [CrossRef]
- Garavand, F.; Rouhi, M.; Razavi, S.H.; Cacciotti, I.; Mohammadi, R. Improving the integrity of natural biopolymer films used in food packaging by crosslinking approach: A review. Int. J. Biol. Macromol. 2017, 104, 687–707. [Google Scholar] [CrossRef]
- Shankar, S.; Rhim, J.W. Preparation of antibacterial poly (lactide)/poly (butylene adipate-co-terephthalate) composite films incorporated with grapefruit seed extract. Int. J. Biol. Macromol. 2018, 120, 846–852. [Google Scholar] [CrossRef]
- Sanuja, S.; Agalya, A.; Umapathy, M.J. Studies on magnesium oxide reinforced chitosan bionanocomposite incorporated with clove oil for active food packaging application. Int. J. Polym. Mater. Polym. Biomater. 2014, 63, 733–740. [Google Scholar] [CrossRef]
- Aji, A.I.; Praseptiangga, D.; Rochima, E.; Joni, I.M.; Panatarani, C. Optical transparency and mechanical properties of semi-refined iota carrageenan film reinforced with SiO2 as food packaging material. AIP Conf. Proc. 2018, 1927, 030039. [Google Scholar]
- Chivrac, F.; Pollet, E.; Avérous, L. Nonisothermal crystallization behavior of poly (butylene adipate-co-terephthalate)/clay nano-biocomposites. J. Polym. Sci. Part B Polym. Phys. 2007, 45, 1503–1510. [Google Scholar] [CrossRef]
- Gadang, V.; Hettiarachchy, N.; Johnson, M.; Owens, C. Evaluation of Antibacterial Activity of Whey Protein Isolate Coating Incorporated with Nisin, Grape Seed Extract, Malic Acid, and EDTA on a Turkey Frankfurter System. J. Food Sci. 2008, 73, M389–M394. [Google Scholar] [CrossRef] [PubMed]
- Figueroa-Lopez, K.J.; Andrade-Mahecha, M.M.; Torres-Vargas, O.L. Development of Antimicrobial Biocomposite Films to Preserve the Quality of Bread. Molecules 2018, 23, 212. [Google Scholar] [CrossRef] [PubMed] [Green Version]
- Martínez-Castañón, G.A.; Niño-Martínez, N.; Martínez-Gutierrez, F.; Martínez-Mendoza, J.R.; Ruiz, F. Synthesis and antibacterial activity of silver nanoparticles with different sizes. J. Nanoparticle Res. 2008, 10, 1343–1348. [Google Scholar] [CrossRef]
- Venkatesan, R.; Thiyagu, T.T.; Rajeswari, N. Zinc composite materials and food packaging. Compos. Mater. Food Packag. 2018, 153–175. [Google Scholar] [CrossRef]
- Venkatesan, R.; Rajeswari, N. Nanosilica-reinforced poly (butylene adipate-co-terephthalate) nanocomposites: Preparation, characterization and properties. Polym. Bull. 2019, 76, 4785–4801. [Google Scholar] [CrossRef]
- Raja, V.; Natesan, R.; Thiyagu, T. Preparation and Mechanical Properties of Poly (butylene adipate-co-terephthalate) Polyvinyl Alcohol/SiO2 Nanocomposite Films for Packaging Applications. J. Polym. Mater. 2015, 32, 93. [Google Scholar]
- Corrales, M.; Han, J.H.; Tauscher, B. Antimicrobial properties of grape seed extracts and their effectiveness after incorporation into pea starch films. Int. J. Food Sci. Technol. 2009, 44, 425–433. [Google Scholar] [CrossRef]
- Balan, G.C.; Paulo, A.F.; Correa, L.G.; Alvim, I.D.; Ueno, C.T.; Coelho, A.R.; Ströher, G.R.; Yamashita, F.; Sakanaka, L.S.; Shirai, M.A. Production of Wheat Flour/PBAT Active Films Incorporated with Oregano Oil Microparticles and Its Application in Fresh Pastry Conservation. Food Bioprocess Technol. 2021, 14, 1587–1599. [Google Scholar] [CrossRef]
- Sharma, C.; Dhiman, R.; Rokana, N.; Panwar, H. Nanotechnology: An Untapped Resource for Food Packaging. Front. Microbiol. 2017, 8, 1735. [Google Scholar] [CrossRef] [Green Version]
- Hajizadeh, H.; Peighambardoust, S.J.; Peighambardoust, S.H.; Peressini, D. Physical, mechanical, and antibacterial characteristics of bio-nanocomposite films loaded with Ag-modified SiO2 and TiO2 nanoparticles. J. Food Sci. 2020, 85, 1193–1202. [Google Scholar] [CrossRef]
- Sharma, S.; Barkauskaite, S.; Jaiswal, S.; Duffy, B.; Jaiswal, A.K. Development of essential oil incorporated active film based on biodegradable blends of poly (lactide)/poly (butylene adipate-co-terephthalate) for food packaging application. J. Packag. Technol. Res. 2020, 4, 235–245. [Google Scholar] [CrossRef]
- Rubilar, J.F.; Cruz, R.M.S.; Silva, H.D.; Vicente, A.A.; Khmelinskii, I.; Vieira, M.C. Physico-mechanical properties of chitosan films with carvacrol and grape seed extract. J. Food Eng. 2013, 115, 466–474. [Google Scholar] [CrossRef] [Green Version]
- Thiyagu, T.T.; Gokilakrishnan, G.; Uvaraja, V.C.; Maridurai, T.; Prakash, V.R. Effect of SiO2/TiO2 and ZnO nanoparticle on cardanol oil compatibilized PLA/PBAT biocomposite packaging film. Silicon 2022, 14, 3795–3808. [Google Scholar] [CrossRef]
- Cho, K.H.; Park, J.E.; Osaka, T.; Park, S.G. The study of antimicrobial activity and preservative effects of nanosilver ingredient. Electrochim. Acta 2005, 51, 956–960. [Google Scholar] [CrossRef]

| Formulated Films | Sample Code | Composition | ||
|---|---|---|---|---|
| PBAT (wt%) | Grape Seed Oil (wt%) | Nanosilica (wt%) | ||
| PBAT | Sample A | 100.0 | 0.0 | 0.0 |
| PBAT/GEO (95:5:0) | Sample B | 95.0 | 5.0 | 0.0 |
| PBAT/GEO (90:10:0) | Sample C | 90.0 | 10.0 | 0.0 |
| PBAT/GEO/SiO2NP (89:10:1) | Sample D | 89.0 | 10.0 | 1.0 |
| PBAT/GEO/SiO2NP (87:10:3) | Sample E | 87.0 | 10.0 | 3.0 |
| Film Samples | % Crystallinity = (Area of the Crystalline Peaks/Total Area Peaks) × 100 |
|---|---|
| A | 12.31 |
| B | 11.56 |
| C | 10.46 |
| D | 16.31 |
| E | 19.74 |
| Composite Samples | Thickness (Microns) | Tensile Strength (MPa) | Elongation at Break (%) | Tensile Modulus (MPa) |
|---|---|---|---|---|
| A | 89 | 35 | 590 | 3.5 |
| B | 85 | 28 | 612 | 2.3 |
| C | 82 | 23 | 625 | 1.9 |
| D | 84 | 38 | 203 | 3.6 |
| E | 83 | 43 | 595 | 3.9 |
| Film Samples | Lightness (L*) | Redness, Greenness (a*) | Yellowness, Blueness (b*) | Total Color Difference (∆E) | Opacity (%) |
|---|---|---|---|---|---|
| A | 90.5 | −1.45 | 5.13 | NA | 46.7 |
| B | 86.24 | −1.19 | 4.28 | 4.35 | 42.3 |
| C | 86.53 | −1.09 | 5.83 | 4.04 | 37.6 |
| D | 84.85 | −1.31 | 6.10 | 5.73 | 45.2 |
| E | 82.80 | −1.88 | 6.03 | 7.76 | 47.1 |
| Film Samples | Zone Inhibition (mm) | |
|---|---|---|
| E. coli | S. aures | |
| A | ND | ND |
| B | 7 | 5 |
| C | 9 | 7 |
| D | 12 | 9 |
| E | 14 | 11 |
Publisher’s Note: MDPI stays neutral with regard to jurisdictional claims in published maps and institutional affiliations. |
© 2022 by the authors. Licensee MDPI, Basel, Switzerland. This article is an open access article distributed under the terms and conditions of the Creative Commons Attribution (CC BY) license (https://creativecommons.org/licenses/by/4.0/).
Share and Cite
Arumugam, S.; Kandasamy, J.; Thiyaku, T.; Saxena, P. Effect of Low Concentration of SiO2 Nanoparticles on Grape Seed Essential Oil/PBAT Composite Films for Sustainable Food Packaging Application. Sustainability 2022, 14, 8073. https://doi.org/10.3390/su14138073
Arumugam S, Kandasamy J, Thiyaku T, Saxena P. Effect of Low Concentration of SiO2 Nanoparticles on Grape Seed Essential Oil/PBAT Composite Films for Sustainable Food Packaging Application. Sustainability. 2022; 14(13):8073. https://doi.org/10.3390/su14138073
Chicago/Turabian StyleArumugam, Soundhar, Jayakrishna Kandasamy, Thendral Thiyaku, and Prateek Saxena. 2022. "Effect of Low Concentration of SiO2 Nanoparticles on Grape Seed Essential Oil/PBAT Composite Films for Sustainable Food Packaging Application" Sustainability 14, no. 13: 8073. https://doi.org/10.3390/su14138073






